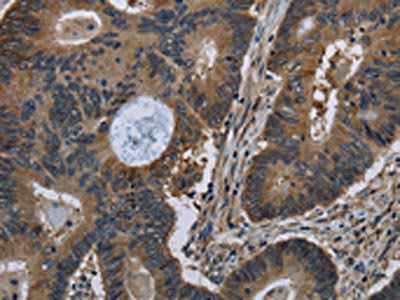

TSC22D3 Antibody
-
中文名稱:TSC22D3兔多克隆抗體
-
貨號:CSB-PA209085
-
規(guī)格:¥1100
-
圖片:
-
The image on the left is immunohistochemistry of paraffin-embedded Human colon cancer tissue using CSB-PA209085(TSC22D3 Antibody) at dilution 1/40, on the right is treated with fusion protein. (Original magnification: ×200)
-
The image on the left is immunohistochemistry of paraffin-embedded Human liver cancer tissue using CSB-PA209085(TSC22D3 Antibody) at dilution 1/40, on the right is treated with fusion protein. (Original magnification: ×200)
-
-
其他:
產(chǎn)品詳情
-
Uniprot No.:
-
基因名:TSC22D3
-
別名:Delta sleep-inducing peptide immunoreactor antibody; DIP antibody; DSIP immunoreactive leucine zipper protein antibody; DSIP-immunoreactive peptide antibody; Dsip1 antibody; Dsipi antibody; GILZ antibody; Glucocorticoid-induced leucine zipper protein antibody; hDIP antibody; Protein DIP antibody; T22D3_HUMAN antibody; TSC-22-like protein antibody; TSC-22-related protein antibody; TSC-22R antibody; TSC22 domain family protein 3 antibody; TSC22 domain family, member 3 antibody; TSC22 related inducible leucine zipper 3 antibody; TSC22D3 antibody
-
宿主:Rabbit
-
反應(yīng)種屬:Human,Mouse,Rat
-
免疫原:Fusion protein of Human TSC22D3
-
免疫原種屬:Homo sapiens (Human)
-
標(biāo)記方式:Non-conjugated
-
抗體亞型:IgG
-
純化方式:Antigen affinity purification
-
濃度:It differs from different batches. Please contact us to confirm it.
-
保存緩沖液:-20°C, pH7.4 PBS, 0.05% NaN3, 40% Glycerol
-
產(chǎn)品提供形式:Liquid
-
應(yīng)用范圍:ELISA,IHC
-
推薦稀釋比:
Application Recommended Dilution ELISA 1:2000-1:5000 IHC 1:50-1:200 -
Protocols:
-
儲存條件:Upon receipt, store at -20°C or -80°C. Avoid repeated freeze.
-
貨期:Basically, we can dispatch the products out in 1-3 working days after receiving your orders. Delivery time maybe differs from different purchasing way or location, please kindly consult your local distributors for specific delivery time.
-
用途:For Research Use Only. Not for use in diagnostic or therapeutic procedures.
相關(guān)產(chǎn)品
靶點詳情
-
功能:Protects T-cells from IL2 deprivation-induced apoptosis through the inhibition of FOXO3A transcriptional activity that leads to the down-regulation of the pro-apoptotic factor BCL2L11. In macrophages, plays a role in the anti-inflammatory and immunosuppressive effects of glucocorticoids and IL10. In T-cells, inhibits anti-CD3-induced NFKB1 nuclear translocation. In vitro, suppresses AP1 and NFKB1 DNA-binding activities. Isoform 1 inhibits myogenic differentiation and mediates anti-myogenic effects of glucocorticoids by binding and regulating MYOD1 and HDAC1 transcriptional activity resulting in reduced expression of MYOG.
-
基因功能參考文獻(xiàn):
- The mRNA expression of GILZ was significantly correlated with Systemic Lupus Erythematosus Disease Activity Index score. PMID: 28601944
- We propose a novel role of GILZ in contributing to corticoid-induced leptin and leptin receptor expression in osteoarthritis synovial fibroblasts PMID: 27716396
- TSC22D3 gene expression is significantly associated with long-term changes in Blood Pressure, providing a link between gene expression and Blood Pressure. PMID: 28784648
- Overall, these results suggest that GILZ antagonizes the pro-inflammatory effects of TNFa in human adipocytes, and its downregulation in obesity may contribute to adipose inflammation and dysregulated adipokine production, and thereby systemic metabolism. PMID: 27178044
- Under endoplasmic reticulum stress conditions, overexpression of GILZ significantly reduced activation of mitochondrial pathway of apoptosis by maintaining Bcl-xl level. GILZ protein affects the unfolded protein response signaling shifting the balance towards pro-survival signals as judged by down-regulation of CHOP, ATF4, XBP1s mRNA and increase in GRP78 protein level. PMID: 27416758
- results reveal GILZ to be a new actor in apoptosis regulation in neutrophil-like cells involving JNK and Mcl-1. PMID: 26384220
- GILZ is a non-redundant regulator of B cell activity, with important potential clinical implications in systemic lupus erythematosus. PMID: 26612340
- our data suggest that GILZ is a key regulator of macrophage functions. PMID: 25964494
- L-GILZ stabilizes p53 proteins by decreasing p53 ubiquitination and increasing MDM2 ubiquitination. PMID: 25168242
- The N-terminal part of L-GILZ protein is responsible for Ras/L-GILZ protein-to-protein interaction, important for the control of proliferation rate of spermatogonia. PMID: 24993177
- PUVA directly stimulates GILZ expression. PMID: 24215840
- Data show a diminished expression of the anti-inflammatory mediator GILZ in the inflamed vasculature and indicate that GILZ downregulation requires the mRNA binding protein ZFP36. PMID: 24747114
- Inhibition of epithelial injury repair by dexamethasone is mediated in part by activation of GILZ. PMID: 23573276
- study suggests that GILZ variants are not common causes of SCO and NOA in Australian or American men PMID: 23494955
- Exogenous GILZ exerts inhibitory effects on endothelial cell adhesive function via a novel pathway involving modulation of NF-kappaB p65 DNA binding and MAPK activity. PMID: 23729444
- Delta-sleep inducing peptide entrapment and release from polymer hydrogels based on modified polyvinyl alcohol in vitro PMID: 23650723
- DC-SCRIPT serves an important role in regulating GR function in DCs, corepressing GR-dependent upregulation of the tolerance-inducing transcription factor GILZ. PMID: 23440419
- Glucocorticoid-inducible genes GILZ and SGK-1 might be promising candidate markers for hippocampal volume changes relevant for diseases like MDD. PMID: 22832853
- The data showed a MyD88- and TTP-dependent GILZ downregulation in human macrophages upon Toll-like receptor activation. Suppression of GILZ is mediated by mRNA destabilization, which might represent a regulatory mechanism in macrophage activation. PMID: 22539300
- High GILZ mRNA expression was independently associated with increased risk for a high level of posttraumatic stress disorder symptoms. PMID: 22137507
- these results demonstrate that GILZ is a key inhibitor of the mTORC2 pathway. PMID: 21804606
- Data show that together with GILZ, chemokine CX3CL1 emerges as a regulator of cell proliferation, which may be of potential clinical relevance for the selection of the most appropriate treatment for EOC patients. PMID: 21750716
- UL14 of herpes simplex virus type 1 interacts with cellular factor TSC22D3 during replication. PMID: 21512757
- The glucocorticoid-induced leucine zipper protein GILZ is a glucocorticoid-responsive molecule with signal transduction interactions, many of which are operative in inflammatory diseases; it could be a key endogenous regulator of the immune response. PMID: 21556028
- Taking into account the unique role of DCs within the allo-HSCT context, novel preventive and curative therapeutics for GVHD might be based on the selective induction of GILZ expression in vivo PMID: 20970683
- GILZ1 inhibits SGK1 ubiquitinylation and subsequent proteasome-mediated degradation, thereby prolonging its half-life and increasing its steady-state expression. PMID: 20947508
- GILZ expression provokes a Crm-1-dependent nuclear exclusion of FOXO3 leading to its relocalization to the cytoplasm. PMID: 20018851
- Implication of the transcription factor GILZ in the pathophysiology of glucocorticoid-induced osteoporosis by regulating osteoblast maturation and bone turnover. PMID: 19875485
- GILZ activates AKT, a crucial signaling molecule in tumorigenesis appearing as a potential key molecule in epithelial ovarian cancer. PMID: 19814803
- Glucocorticoids and IL-10 stimulated macrophage production of GILZ, which displayed activities related to anti-inflammatory and immunosuppressive effects. PMID: 12393603
- GILZ is a transiently expressed protein induced upon IL-2 withdrawal that protects T cells from the onset of apoptosis. PMID: 15031210
- Overexpression of the Forkhead transcription factor FoxO3 enhances GC-induced gilz mRNA expression. PMID: 15705665
- analysis of a novel link between GILZ and regulation of epithelial sodium transport through modulation of ERK signaling PMID: 16216878
- GILZ is critical for commitment of DCs to differentiate into regulatory DCs and to the generation of antigen-specific Tregs. PMID: 17356131
- multiple GILZ isoforms are expressed in most cells and tissues and that these play distinct roles in regulating proliferation and ion transport. PMID: 17956870
- Lower basal plasma cortisol levels and a lower expression of corticosteroid receptors and GILZ in fibromyalgia patients when compared to healthy controls. PMID: 18468809
- GILZ is a mediator of glucocorticoid killing, and is regulated by PI3-kinase/AKT. PMID: 18499442
- Down-regulated expression of GILZ may contribute to the pathogenesis of CRSsNP and CRSwNP and associate with response to surgery. GILZ expression in the upper airways can be regulated differentially by different cytokines. PMID: 19260870
- GILZ1 and SGK1 provide a physical and functional link between the PI3K- and Raf-1-dependent signaling modules PMID: 19380724
顯示更多
收起更多
-
亞細(xì)胞定位:[Isoform 1]: Cytoplasm. Nucleus.
-
蛋白家族:TSC-22/Dip/Bun family
-
組織特異性:Expressed in brain, lung, spleen and skeletal muscle. Lower levels detected in heart and kidney. Not detected in the pancreas. In non-lymphoid tissues, in the absence of inflammation, the major source of constitutive expression is the macrophage lineage.
-
數(shù)據(jù)庫鏈接:
Most popular with customers
-
-
YWHAB Recombinant Monoclonal Antibody
Applications: ELISA, WB, IHC, IF, FC
Species Reactivity: Human, Mouse, Rat
-
Phospho-YAP1 (S127) Recombinant Monoclonal Antibody
Applications: ELISA, WB, IHC
Species Reactivity: Human
-
-
-
-
-